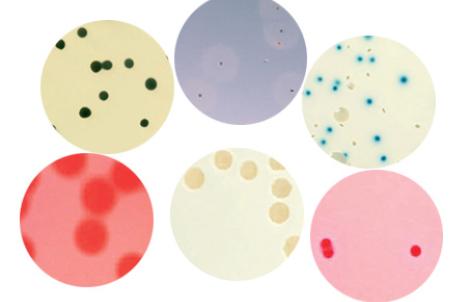
Meat-Liver Sulfite Iron Agar | Bio-Rad Laboratories

订购
items
Use the filters below to refine results!
(停产) Meat-Liver Sulfite Iron/Agar
3554770
100 ml x 6 bottles
(停产) Meat-Liver Sulfite Iron/Agar
3554777
20 ml x 25 tubes
(停产) Meat-Liver Sulfite Iron/Agar
3554794
7.5 ml x 25 tubes
(停产) Meat-Liver Sulfite Iron/Agar
3569654
500 g
